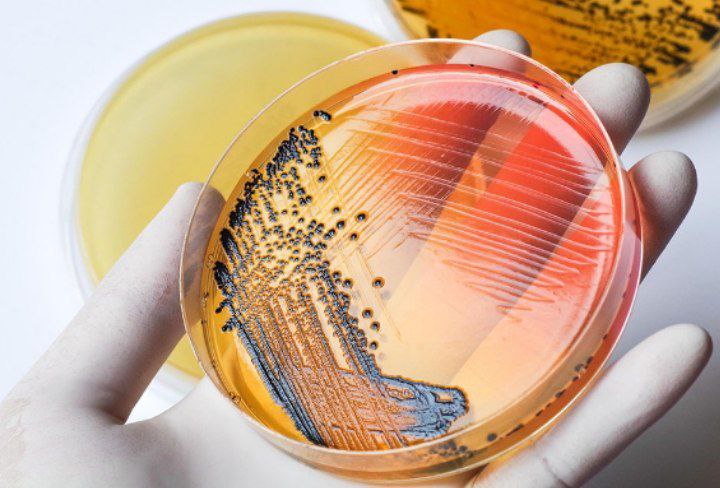

❓Kolit nima va uning belgilari qanday? ✔️Kolit — yo‘g‘on ichakni qoplab turuvchi shilliq pardaning yallig‘lanish kasalligi. U me’da-ichak yo‘lining eng ko‘p tarqalgan kasalliklaridan biri bo‘lib, me’da va ingichka ichak shilliq qavatining yallig‘lanishi bilan birga davom etib, gastroenterokolitga olib kelishi mumkin. ✔️Kolit…

✅Issiqlik urishi – tashqi yuqori haroratning uzoq vaqt ta’siri natijasida tananing umumiy qizib ketishi (yozda koʻchada, hammom va sauna kabi yopiq xonalarda, jamoat transportida). Bundan tashqari, zich sintetik kiyim ham tananing qizib ketishiga olib keladi. ✅Quyosh urishi – quyosh nuri boshga uzoq…

✔️Zira—ishtaxani yaxshilash uchun hamda oshqozondagi sanchiq, oʻt pufagi va jigardagi ogʻriqlar, shuningdek, yoʻtalga qarshi foydali tabiiy vositadir. ✔️Tarkibidagi shifobaxsh taʼsir etadigan moddalar: ✔️zira tarkibi 3—7 % efir moyidan, 12—22 yogʻli moydan, shuningdek, kversetin va kempferol deb nomlanuvchi flavonoidlar, kumarinlar, umbelliferon, skopoletin va boshqa moddalardan iborat. Bundan tashqari unda…

❓Botulizmga nima sabab bo’ladi? ✅Botulizm botulina bakteriyalari (va boshqa Clostridium turlari) tomonidan sintez qilinadigan neyrotoksinlar sabab rivojlanadi. Toksin kasallikni keltirib chiqaradi va u nervlar uchlarida asetilxolinning tarqalishini oldini oladi. Ushbu natija botulizm bilan bog’liq alomatlarga olib keladi. ❓Botulizm uchun xavf…

✅Dezinfeksiya tushunchasi ✅Dezinfeksiya (dez va infeksiya), yuqumsizlantirish yuqumli kasalliklarni qoʻzgʻatuvchi mikroorganizmlar (bakteriyalar, viruslar va boshqalar)ni yoʻq qilish. ✅Profilaktik, kundalik, yakunlovchi dezinfeksiya boʻladi. ✅Profilaktik dezinfeksiya yuqumli kasalliklarning oldini olish maqsadida uy anjomlari, idish-tovoklarni, jamoat toʻplanadigan joylar (bozor, doʻkon, bolalar muassasasi, hammom,…
📌Salmonellyoz — bu salmonella avlodiga mansub bakteriyalar tomonidan keltirib chiqariladigan, fekal-oral mexanizm bilan yuqadigan, asosan oshqozon-ichak traktining zararlanishi bilan kechadigan o’tkir yuqumli kasallik hisoblanadi. 📌Kasallikning kechish tabiati har bir holatda farq qilib, alomatlarsiz shikastlanishdan to toksik va degidratatsion shok darajasigacha boradi.…

❓Gepatit D kasalligida qanday parhez tavsiya etiladi? ✅Davolash paytida 5-sonli parhez buyuriladi. ✅Quyidagilar mumkin emas: ✅yog’li go’sht, baliq sho’rvalari; ✅go’sht, baliq, parranda go’shtining yog’li navlari; ✅konserva, dudlangan go’sht, marinadlar; ✅non; ✅yog ‘ mahsulotlari; ✅qaynatilgan tuxum; ✅meva, rezavorlarning nordon navlari; ✅piyoz,…
